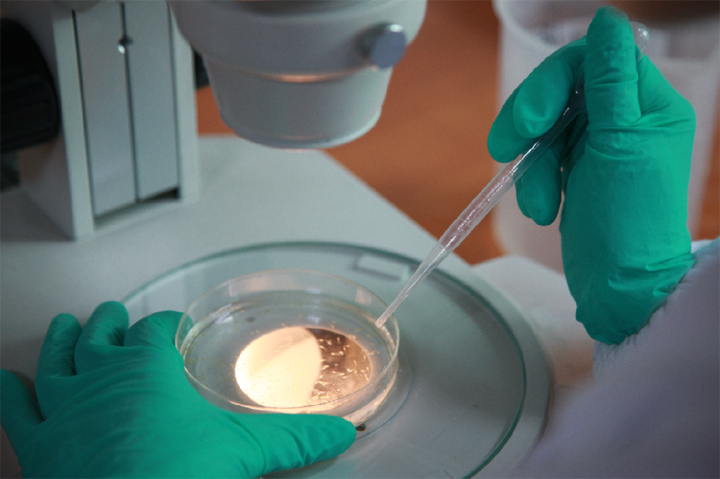
新闻图片5

13 年
手机商铺
入驻年限:13 年
成经理
浙江 杭州市 滨江区
实验室仪器 / 设备、抗体、试剂、细胞库 / 细胞培养、论文服务、技术服务
生产厂商 科研机构
公司新闻/正文
1895 人阅读发布时间:2022-07-12 18:10

7月9日,在热门综艺《为歌而赞》露营歌会之旅中,张信哲、凤凰传奇成员曾毅、陈楚生等一众明星大咖们打卡君乐宝斑马鱼实验室,一探奶粉高端奥秘。
“产奶的地方怎么会有鱼?”“这是观赏鱼吗?”“是不是用它们来调节心情?”……在君乐宝食品安全中心,“我们是用它们来检测奶粉是否安全的!”,君乐宝建立的基于斑马鱼的安全风险预警机制,全面刷新了众明星对国产奶粉安全检测的认知,引得众明星啧啧称奇。这一刻,“斑马鱼"这一科研界的明星斑马鱼,在“明星”们的加持下,成功出圈!

环特生物,作为君乐宝乳业战略合作伙伴,通过十余年的斑马鱼技术创新应用实践,不仅助力君乐宝建立了基于斑马鱼的安全风险预警机制,而且与其在斑马鱼实验室建设及业界的乳品生物学质控体系建设等方面达成了深度合作。针对婴幼儿奶粉的安全性,从品质分级、安全预警、未知风险物质筛查以及长期服用风险评价等方面,率先实现产品生物学层面的质控标准新跃升,从而开创了乳企“理化+生物”检测的质控管理新格局。
一、为什么是斑马鱼?

近年来,人们对健康愈发关注,“新鲜、营养、保留活性因子”的低温奶市场发展迅速,越来越多的乳企在产品及原料功效及安全性等方面不断提升,力求为市场提供更有效、更安全的健康奶,真正从源头守护人类健康。
基于此,在乳品质量控制过程中,以“水中小白鼠”斑马鱼代替人类试吃、试用,全面检测有关产品及成分的安全性和功效,作为对现有乳品检测技术和品质评价体系方法的一种有效补充,为优质乳品的筛选和评价提供了一种新方法。

斑马鱼,作为继大小鼠之后的全球第三大模式动物,其与人类的基因同源性高达87%,生理、发育和代谢与哺乳类动物高度相似,能可靠模拟和预测人类生理、病理过程。因此,斑马鱼模型已被科学家们广泛应用于人类各种疾病的研究及功能性食品、化妆品、药品的功效及安全性评价中。
特别值得一提的是,根据欧盟动物保护法,出生5天以内的斑马鱼胚胎和幼鱼不属于动物,可用于替代哺乳动物测试,符合3R(替代、减少、优化)原则。
二、斑马鱼加码护航乳品品质
自2019年以来,环特生物与国内乳业龙头企业——君乐宝乳业、伊利股份、蒙牛乳业、光明乳业、飞鹤乳业等持续开展深度合作,为乳品品质加码护航。
凭借在斑马鱼技术领域逾20年的深厚积累,环特生物以斑马鱼技术为核心,深度挖掘、创新斑马鱼技术的应用场景,将斑马鱼生物评价技术和基因编辑技术成功应用于乳制品、保健食品、化妆品、药品、食品的配方研发、原料筛选、生产质控、营销背书、新品备案及斑马鱼实验室的建设运营,为企业提供全产业链条上的功效和安全评价验证服务。
除了将环特生物纳入供应商平台,采用斑马鱼技术进行原料筛选、配方筛选优化等,2021年以来,环特生物与君乐宝乳业、伊利股份、蒙牛乳业等知名乳企的合作范围已扩展到乳品基础研究、产品验证、质控体系打造、斑马鱼实验室建设、项目成果申报、标准共建等多方面,使斑马鱼技术产学研用深度融合,助力乳企把技术创新资源优势转化为高质量发展优势,为中国乳企崛起加码助力。

作为君乐宝乳业战略合作伙伴,环特生物通过十余年的斑马鱼技术创新应用实践,助力其斑马鱼实验室建设及业界的乳品生物学质控体系建设。针对婴幼儿奶粉的安全性,从品质分级、安全预警、未知风险物质筛查以及长期服用风险评价等方面,率先实现产品生物学层面的质控标准新跃升,从而开创了乳企“理化+生物”检测的质控管理新格局。

未来,环特生物将联合更多的乳企,顺应健康市场的发展,以斑马鱼的“破圈之力”,以斑马鱼生物评价技术和基因编辑技术服务解决方案,深度发掘斑马鱼生物科技的潜在应用价值,以好技术护航好品质,以科学助力更多乳企发展,推动奶业振兴!